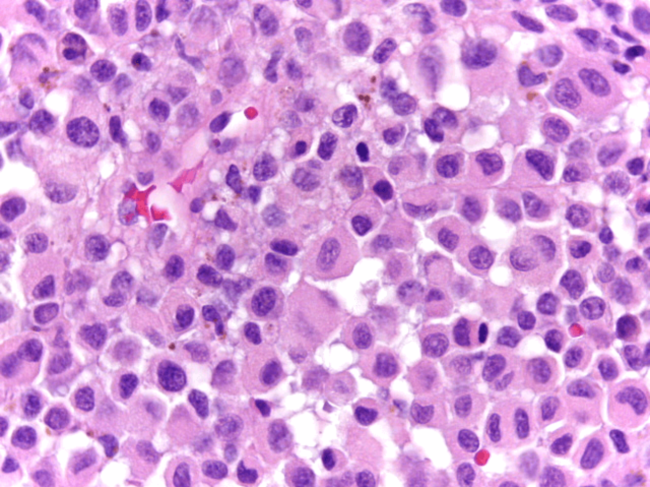

Unidade de Cancro da Pele
Hospital CUF Descobertas - Lisboa
A Unidade de Cancro da Pele é a unidade de patologia responsável pela organização e convergência de percursos de doentes e protocolos clínicos no diagnóstico e tratamento dos cancros cutâneos, nomeadamente o melanoma, o carcinoma basocelular e o carcinoma espinocelular.
Organização clínica
Na CUF Oncologia, esta unidade de patologia tem uma coordenação a sul e outra a norte do país, de forma a uniformizar e transversalizar as melhores práticas na abordagem aos tumores da pele, nos hospitais e clínicas da rede CUF.
A Unidade de Cancro da Pele é composta por uma equipa multidisciplinar de especialistas no diagnóstico e tratamento destes tumores malignos.
Os nossos doentes e seus cuidadores contam com um acompanhamento de grande proximidade, transmitindo confiança e esperança na recuperação da doença.
Ao seu dispor encontrará enfermeiros dedicados que o acompanham passo a passo para que se sinta sempre seguro e informado e uma equipa de gestores oncológicos, que facilitam todo o processo administrativo.
Coordenação:
Unidade de Cancro da Pele a Sul: Ana Raimundo, Oncologista, e João Maia e Silva, Dermatologista
Unidade de Cancro da Pele a Norte: Cláudia Caeiro, Oncologista, e Ricardo Vieira, Dermatologista
Investigação Clínica
O melanoma nas fases mais avançadas é uma doença de abordagem complexa e com terapias muito especializadas.
Os especialistas da Unidade de Tumores da Pele participam activamente nos projetos de investigação da European Organization for Research and Treatment of Cancer (EORTC). Esta colaboração permite que os nossos médicos possam levar as suas questões clínicas à investigação laboratorial, contribuindo para o desenvolvimento de novos protocolos diagnósticos e tratamentos.
A comunicação entre médicos e cientistas está permanentemente subjacente ao desenvolvimento de tratamentos inovadores que sejam uma verdadeira esperança para os doentes.
Aconselhe-se com o seu médico sobre a possibilidade de integrar um ensaio clínico.
Faça o seu pedido de contacto para o podermos acompanhar desde o primeiro momento.
Se preferir pode agendar uma consulta através da nossa linha gratuita.
As principais especialidades envolvidas no diagnóstico e tratamento dos cancros de pele são:
- Dermatologia
- Cirurgia Geral
- Imagiologia
- Anatomia Patológica
- Medicina Nuclear
- Oncologia Médica
- Radioterapia
Consulta de Dermatologia Oncológica
Esta consulta tem o objectivo de oferecer um atendimento integral a todos os doentes com ou em risco de vir a ter esta doença. Para aumentar a sua acessibilidade, esta consulta funciona de forma integrada e com igual padrão de qualidade em todas as unidades CUF.
Serviços prestados
- Avaliação detalhada e acompanhamento de indivíduos que têm múltiplos “sinais”, têm suspeita de melanoma, ou que estão em alto risco para melanoma.
- Aplicação de técnicas de diagnóstico dirigidas como o registo fotográfico do corpo inteiro, a dermatoscopia digital e a microscopia confocal in vivo.
Os tratamentos são estabelecidos de acordo com os protocolos mais actuais para cada fase da doença e podem envolver procedimentos cirúrgicos, na maior parte dos casos, como a utilização da Cirurgia de Mohs, tratamentos farmacológicos como a quimioterapia ou a imunoterapia e tratamentos de radioterapia.
Quando o melanoma é detectado precocemente pode, na maioria dos casos, ser curado com uma cirurgia simples. Alguns doentes, no entanto, têm um alto risco de recidiva ou propagação deste tumor e exigem um plano de cuidados integrados.
Existe também a oportunidade de participar em programas de investigação e ensaios clínicos.
A CUF Oncologia disponibiliza ainda acompanhamento psicológico, aconselhamento cosmético e educação nutricional.
Serviços Clínicos de Apoio
- Hospital de Dia
- Internamento
- Bloco Operatório
- Cuidados Intensivos
- Cuidados Paliativos
- Atendimento Permanente
- Linha de Apoio 24 horas
- Nutrição
- Onco-psicologia
- Todas as especialidades
O melanoma é um tipo de cancro de pele e a sua incidência está a aumentar em Portugal. Conheça os fatores de risco, sintomas e as formas de o diagnosticar e tratar, disponíveis na rede CUF.

Mais de 95% dos cancros de pele não são do tipo Melanoma. Os mais frequentes são o carcinoma basocelular, ou basalioma, e o carcinoma espinocelular. Conheça os seus fatores de risco e sintomas e tudo o que a rede CUF disponibiliza para o diagnóstico e tratamento destes tumores.
Centros
Os Centros CUF encontram-se organizados de forma multidisciplinar e agregadora, proporcionando um acompanhamento completo com base numa organização assente num percurso clínico de um grupo de doenças, órgãos ou especialidades médicas.
Informações úteis sobre o Hospital: contactos, horários, como chegar.





